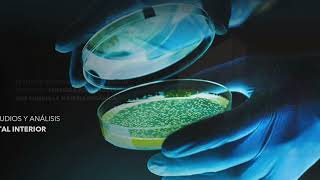

Engineering for Clean Environments. It offers customized solutions in Indoor Environmental Quality (CAI). At INPAL we are committed to the continuous improvement of our equipment, using only supervised and standardized components that allow us to guarantee energy efficiency, minimizing the environmental impact.
We currently offer services ranging from previous studies of environmental conditions, to install or operate equipment and/or components to improve Indoor Environments.
With more than 11 years in the market and more than 300 equipments and installations for all types of applications; we are sure of our ability to provide solutions to your most stringent needs, that is why INPAL invites you to know our catalog of services and offer you an alternative for the solution to your clean air requirement.
Shared 6 months ago
17 views
Shared 9 months ago
4 views
Shared 9 months ago
14 views
Shared 10 months ago
8 views
Shared 11 months ago
16 views
Shared 11 months ago
2 views
Shared 1 year ago
13 views
Shared 1 year ago
5 views
Shared 1 year ago
11 views
Shared 1 year ago
10 views
Shared 1 year ago
4 views
Shared 1 year ago
3 views
Shared 1 year ago
21 views
Shared 1 year ago
5 views
Shared 1 year ago
10 views
Shared 1 year ago
8 views
Shared 1 year ago
22 views
Shared 1 year ago
10 views
Shared 1 year ago
18 views
Shared 1 year ago
22 views
Shared 2 years ago
6 views
Shared 2 years ago
14 views
Shared 2 years ago
15 views
Shared 3 years ago
45 views
Shared 4 years ago
1.8K views
Shared 4 years ago
107 views